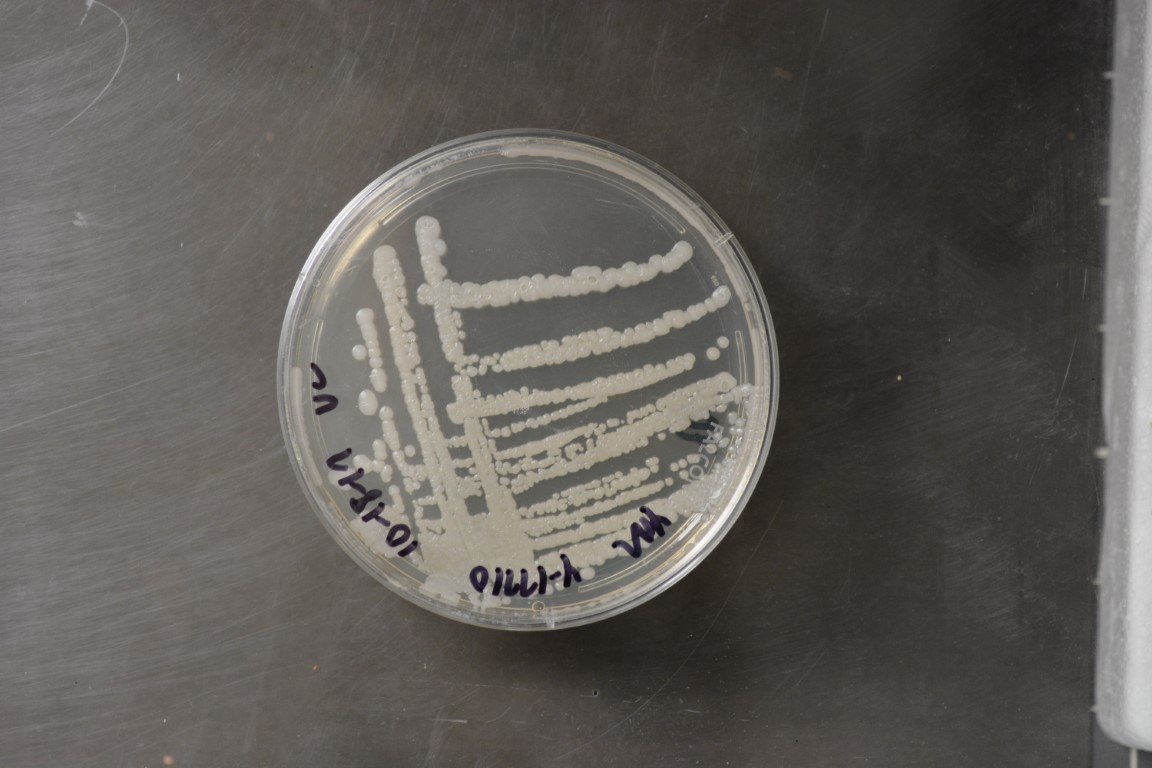

Saccharomycopsis fermentans
NRRL Y-17710(Type Strain)
Accession numbers in other collections:CBS 7830=CCRC 22530=IFO 10772
Source:Chang,Firdi,Taiwan,China
Isolated from(substrate):SL,soil from a papaya orchard
Substrate location:Taiwan
Genetic info:ROBNETT PCR#652.GenBank:D1/D2(U73600),ITS(DQ361059).
Growth media:Yeast Extract-Malt Extract-Peptone-Glucose(YM for yeasts)(number 6)
Optimum growth temperature:25C
Strain images:
NRRL_Y-17710_6.JPG

Comments:ex-holotype